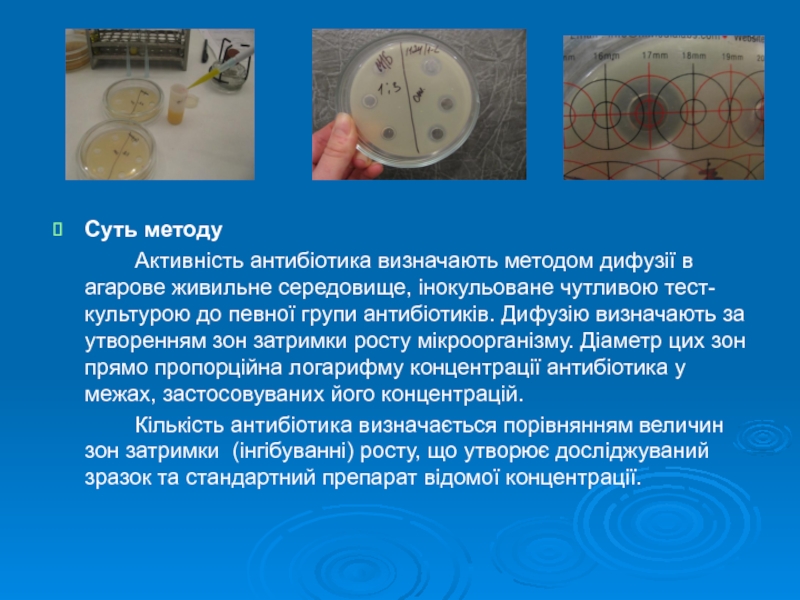

- Главная
- Разное
- Дизайн
- Бизнес и предпринимательство
- Аналитика
- Образование
- Развлечения
- Красота и здоровье
- Финансы
- Государство
- Путешествия
- Спорт
- Недвижимость
- Армия
- Графика
- Культурология
- Еда и кулинария
- Лингвистика
- Английский язык
- Астрономия
- Алгебра
- Биология
- География
- Детские презентации
- Информатика
- История
- Литература
- Маркетинг
- Математика
- Медицина
- Менеджмент
- Музыка
- МХК
- Немецкий язык
- ОБЖ
- Обществознание
- Окружающий мир
- Педагогика
- Русский язык
- Технология
- Физика
- Философия
- Химия
- Шаблоны, картинки для презентаций
- Экология
- Экономика
- Юриспруденция
Удосконалення процедур забезпечення якості результатів випробувань в лабораторії ветеринарної медицини презентация
Содержание
- 1. Удосконалення процедур забезпечення якості результатів випробувань в лабораторії ветеринарної медицини
- 2. Актуальність: Впровадження вимог ISO/IEC 17025:2005 є обов’язковою
- 3. Мета, об’єкт дослідження: Мета дослідження – удосконалити
- 4. Завдання: Ідентифікувати та описати процес випробувань продукції
- 5. Методи дослідження: порівняння; аналізу; узагальнення; системного підходу.
- 6. Регіональна державна лабораторія ветеринарної медицини (РДЛВМ) в
- 7. Розробка процедури випробувань визначення залишкової кількості антибіотиків
- 8. Суть методу Активність антибіотика визначають методом дифузії
- 9. Розробка оцінки придатності мікробіологічного методу при проведенні
- 10. Розроблення елементів системи автоматизованого управління лабораторією для
- 11. Дякую за увагу вельмишановні члени комісії!
Слайд 1 Магістерська робота Загороднюк Марини Юріївни На тему: «Удосконалення процедур забезпечення якості
Слайд 2Актуальність:
Впровадження вимог ISO/IEC 17025:2005 є обов’язковою задачею для всіх лабораторій, що
Необхідність наявності у виробничих лабораторіях процедур з контролю якості результатів випробувань регламентується даним стандартом який підтверджує компетентність таких лабораторій шляхом акредитації в НААУ та забезпечує якість (вірогідність) результатів випробувань.
Слайд 3Мета, об’єкт дослідження:
Мета дослідження – удосконалити процедуру випробувань на дослідження антибіотиків
Об’єкт дослідження – забезпечення якості результатів випробувань в лабораторії ветеринарної медицини.
Слайд 4Завдання:
Ідентифікувати та описати процес випробувань продукції тваринництва на вміст антибіотиків мікробіологічним
Розробити документовану процедуру проведення випробувань вмісту антибіотиків.
Розробити та реалізувати схему валідації мікробіологічного методу визначення антибіотиків.
Розробити та впровадити забезпечення якості процедури результатів випробувань мікробіологічним методом визначення антибіотиків та підходи щодо оцінки їх ефективності.
Слайд 6Регіональна державна лабораторія ветеринарної медицини (РДЛВМ) в Київській області
Лабораторія акредитована в
Загальна структура РДЛВМ в Київській області у підпорядкуванні Головного управління ветмедицини в Київській обл.:
Державний комітет ветеринарної медицини
І
Державний науково-дослідний інститут з лабораторної діагностики та вет-сан. експертизи
І
Головне управління ветмедицини в Київській області
І
Регіональна державна лабораторія ветеринарної медицини в Київській області
Слайд 7Розробка процедури випробувань визначення залишкової кількості антибіотиків мікробіологічним методом в продуктах
Процедури випробування детально описують послідовність приготування зразків, виконання певної методики випробування та контролю точності отриманих результатів.
Слайд 8Суть методу
Активність антибіотика визначають методом дифузії в агарове живильне середовище, інокульоване
Кількість антибіотика визначається порівнянням величин зон затримки (інгібуванні) росту, що утворює досліджуваний зразок та стандартний препарат відомої концентрації.
Слайд 9Розробка оцінки придатності мікробіологічного методу при проведенні досліджень на вміст залишкових
Оцінювання придатності (валідація) методу – це підтвердження шляхом дослідження та надання об`єктивних доказів того, що конкретні вимоги до специфічного цільового використання метода виконуються.
Слайд 10Розроблення елементів системи автоматизованого управління лабораторією для напрямку мікробіологічного визначення антибіотиків.
Лабораторна
Комп'ютерна програма LІMS успішно впроваджена в РДЛВМ в Київській області
Виконує вимоги стандартів ISO/IEC 17025:2005 та ДСТУ/ISO/IEC 17025:2006.